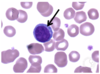
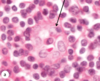

Written Exam 2 Flashcards
(239 cards)
What does the skin do?
- Protective (barrier)
- Minimize water loss
- Prevent entry of pathogens
- UV radiation
- Physical forces
- Sensory
- Body temp regulation
- Produce vitamin D
What layer of the skin are epithelial cells found?
Epidermis
(epi = epi)
Name and describe the layers that make up the skin
- Epidermis (Epi = on top of)
- Dermis
- CT under the epidermis
- Hypodermis (hypo = below)
- CT under the dermis
- Lots of adipose tissue!
- CT under the dermis

Explain the difference between thick skin and thin skin and where each are found
-
Thick skin:
- Found in palm of hands and bottom of feet
- Lots of keratinized epithelium
- thick epidermis
- Varies a lot (differentiation point between thickness of skin)
- smaller dermis
- Found in palm of hands and bottom of feet
-
Thin skin:
- Found everywhere on skin but palms of hands and bottom of feet
- Skinnier epidermis
- Not as much keratinized epithelium
- Thicker dermis

What is skin cancer and why can there be several types?
Cancer = uncontrolled cell growth
How can there be several types?
There is more than one type of cell in the skin
What are the cells found in the epidermis, what type of cancer can be found in each cell type and where they are located?
- Basal Cells = Basal cell carcinoma
- Keratinocytes = squamous cell carconoma (flat c)
- Squamous cells = squamous cell carconoma
-
Melanocytes = melanoma (pigmented moles)
- In basal layer
-
Merkel cells = Merkel cell carcinoma
- In basal layer
-
Langerhans cells = Immune cells in epidermis
- Dendritic cells (stratum spinosum)

What is the function of the tactile cells?
Tactile (Merkel) cells
- located in basal layer throughout. Sensory nerve endings attach to these cells

What is the following layer of the epidermis called and what are the distinct characteristics?

Stratum Basale
(layer base)
- One cell layer thick
- cuboidal or columnar cells
- contain demidesmosomes to attach to CT under
- mitotic cells - stem cells, production of new cells
- contain desmosomes to attach to each other

What is the following layer of the epidermis called and what are the distinct characteristics?
(black arrow)

Stratum spinosum
- No hemidesmosomes (does not attach to CT)
- Has desmosomes (attach to each other)
- Some mitotic cells
- Thicker in thick skin than thin
- Active cells => makes protein (keratin)

Explain the function/process of keratinocytes and where they are located in the epidermis
Keratinocytes in the stratum spinosum
>>>>>
producing keratin
>>>>>
Makes up the intermediate filaments (made of keratin) in the epithelial cells of the skin
(tonofibrils) = special name
Remember: intermediate filaments are involved in intracellular adhesion
Which type of junction involves the intermediate filament?
Desmosomes
= integrins

Explain the components in the following EM slide

Keratinocytes in the stratum spinosum
- Tonofibrils of keratin = dark lines
- intermediate filaments
- Cytoplsamic extensions
- Desmosomes
- electron dense

Describe the following slide

Keratinocytes in the stratum spinosum
(looks like a spine = prickly)
- What would you say about the nuclei?
-
Euchromatic = active
- DNA dispersed
-
Euchromatic = active
- Looks prickly or spiny = cytoplasmic extension

What is the following layer of the epidermis called and what are the distinct characteristics?
(black arrow)

Stratum granulosum
- squamous shape
- Only 3 to 5 layers thick
- Cells develop a lipid envelope (water resistance)
- Cytoplasm has Basophilic masses
- Hemotoxylin staining

Explain a summary of the differentiation of cells in the stratum granulosum

-
Cells contain many keratohyaline granules
- Contain several proteins, including profilaggrin
- Granules stain w/hematoxylin = dark color
-
Cells also contin many lamellar grandules
- contain several substances, including lipids
- The nucleus and other organelles degrade and the cells begin to die in this layer

Explain a summary of the keratinization of cells in the stratum granulosum
-
Proflaggrin is proteolysed into multiple filagrin monmers.
- Free filaggrin binds to keratin intermediate filaments, causing aggregation into macrofibrils
- intermediate filaments aligned in tightly packed parallel arrays
- Free filaggrin binds to keratin intermediate filaments, causing aggregation into macrofibrils
-
Lipids and other substances are secreted from lamellar granules
- forming a lipid barrier encircling the cell
- Lipid + filaggrin + keratin matrix = important skin barrier

Explain the end result of keratinization in the stratum granulosum layer of the epithelium
End result of keratinization -> cornified cell
Compressed keratin + filaggrin
-
Contains lipid envelope:
- Prevents abrasion
- Prevents desication
- Protects form infection

What is the following layer of the epidermis called and what are the distinct characteristics?
(black arrow)

Stratum lucidum
- light layer above the stratum granulosum
- ONLY in thick skin
- Cells that lost their organelles
- Contain desmosomes = cells still attached to each other

What are the following structures in this slide?

stratum lucidium = light layer
stratum granulosum = dark layer

What is the following layer of the epidermis called and what are the distinct characteristics?
(black arrow)

Stratum corneum
- Very thick in thick skin and very thin in thin skin
Non nucleated, keratinized cells called squames or cornified cells
- Contains loose desmosomes
- Cells at surface begin to sluff off as the desmosomes break down
- Keratin dust

Where are melanocytes located?
What is the function of melanocytes?
- Melanocytes = dispersed throughout the stratum basale
- Melanin is packaged in small special vesicles called = melanosomes
- Melanocytes have cytoplasmic extensions or dendrites. The melanosomes mature and move to the tip of the dentrite
- The tip of the dendrites with the melanosomes is engulfed by keratinocytes and the melanosomes move towards the nucleus
- Produce melanin and transfer it to keratinocytes
- Tip of the melanocyte gets moved/bit off and goes to the keratinocyte

What is the following cell?

Melanocyte
Can tell it is a melanocyte because of the hollow (clear area)
- Error from the tissue processing
Melanin capping the nucleus of a keratinocyte

Why does melanin accumulate in this supranuclear cap?

Protects DNA from UV radiation
- All skin color has the SAME DENSITY of melanocytes, however there may be LESS MELANIN IN KERATINOCYTES
What are these brown stained cells?

Langerhans Cells
- Immune cells
Type of dendritic cells